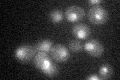
YMR233W
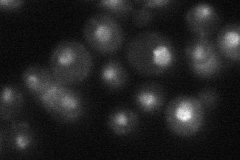
YMR233W
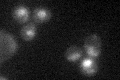
YMR233W

View description
Non-essential sumoylated protein of unknown function with similarity to components of human SWI/SNF complex including SMRD3; green fluorescent protein (GFP)-fusion protein localizes to the cytoplasm, nucleus and nucleolus
Localization:
Intensity:
Fold change:
Significance:
-
C’ GFP library in SD
nucleolus25.06 -
N' NOP1pr-GFP in SD

cytosol,punctate47.3159 -
N' TEF2pr-mCherry in SD

nucleus,nucleolus67.1462 -
N' NATIVEpr-GFP in SD
nucleus,nucleolus23.7516 -
N' TEF2pr-VC and Cyto-VN in SD

nucleus,nucleolus31.6152 -
C’ GFP library in SD+DTT

nucleolus22.580.9No -
C’ GFP library in SD+H2O2
nucleolus21.420.85No -
C’ GFP library in Starvation Media

nucleolus25.020.99No -
C’ GFP library on the background of Pup2-DaMP

nucleolus -
C’ GFP library on the background of CCT mutant

nucleolus24.78150.988409No
